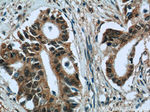
OSGEP Antibody in Immunohistochemistry (Paraffin) (IHC (P))
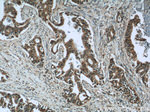
OSGEP Antibody in Immunohistochemistry (Paraffin) (IHC (P))
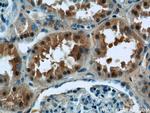
OSGEP Antibody in Immunohistochemistry (Paraffin) (IHC (P))

Search
Proteintech
OSGEP Polyclonal Antibody
{{$productOrderCtrl.translations['antibody.pdp.commerceCard.promotion.promotions']}}
{{$productOrderCtrl.translations['antibody.pdp.commerceCard.promotion.viewpromo']}}
{{$productOrderCtrl.translations['antibody.pdp.commerceCard.promotion.promocode']}}: {{promo.promoCode}} {{promo.promoTitle}} {{promo.promoDescription}}. {{$productOrderCtrl.translations['antibody.pdp.commerceCard.promotion.learnmore']}}
产品信息
15033-1-AP
种属反应
宿主/亚型
分类
类型
抗原
偶联物
形式
浓度
规格
纯化类型
保存液
内含物
保存条件
运输条件
产品详细信息
Immunogen sequence: MPAVLGFEG SANKIGVGVV RDGKVLANPR RTYVTPPGTG FLPGDTARHH RAVILDLLQE ALTESGLTSQ DIDCIAYTKG PGMGAPLVSV AVVARTVAQL WNKPLVGVNH CIGHIEMGRL ITGATSPTVL YVSGGNTQVI AYSEHRYRIF GETIDIAVGN CLDRFARVLK ISNDPSPGYN IEQMAKRGKK LVELPYTVKG MDVSFSGILS FIEDVAHRML ATGECTPEDL CFSLQETVFA MLVEITERAM AHCGSQEALI VGGVGCNVRL QEMMATMCQE RGARLFATDE RFCIDNGAMI AQAGWEMFRA GHRTPLSDSG VTQRYRTDEV EVTWRD (1-335 aa encoded by B C032310)
靶标信息
Osgep (O-sialoglycoprotein endopeptidase), also known as GCPL1, is a 335 amino acid protein that is a member of the peptidase M22 family. Osgep specifically cleaves the 31-Arg-l-Asp-32 bond in glycophorin A, but it does not cleave desialylated glycoproteins, unglycosylated proteins or glycoproteins that are only N-glycosylated. Though ubiquitously expressed at low levels, highest levels of Osgep are found in liver, skeletal muscle and kidney. OSGEPL1, also known as Qri7, is a 414 amino acid protein that belongs to the KAE1/YgjD family and exists as three alternatively spliced isoforms. In tRNAs that have codons beginning with adenine, OSGEPL1 is required for the formation of a threonylcarbamoyl group on adenosine.
仅用于科研。不用于诊断过程。未经明确授权不得转售。
生物信息学
蛋白别名: hOSGEP; mOsgep; N6-L-threonylcarbamoyladenine synthase; O-sialoglycoprotease; O-sialoglycoprotein endopeptidase; O-sialoglycoprotein endopeptidase {ECO:0000255|HAMAP-Rule:MF_03180}; OSGEP; pasteurella haemolytica metalloprotease homolog with glycoprotein substrates/gpc-like protein 1; probable O-sialoglycoprotein endopeptidase; probable tRNA N6-adenosine threonylcarbamoyltransferase; probable tRNA N6-adenosine threonylcarbamoyltransferase {ECO:0000255|HAMAP-Rule:MF_03180}; probable tRNA threonylcarbamoyladenosine biosynthesis protein OSGEP; Prsmg1/Gcpl1; t(6)A synthase; t(6)A37 threonylcarbamoyladenosine biosynthesis protein OSGEP; t(6)A37 threonylcarbamoyladenosine biosynthesis protein Osgep {ECO:0000255|HAMAP-Rule:MF_03180}; tRNA N6-adenosine threonylcarbamoyltransferase; tRNA threonylcarbamoyladenosine biosynthesis protein OSGEP; tRNA threonylcarbamoyladenosine biosynthesis protein Osgep {ECO:0000255|HAMAP-Rule:MF_03180}; unnamed protein product
基因别名: 1500019L24Rik; GAMOS3; GCPL-1; GCPL1; KAE1; OSGEP; OSGEP1; PRSMG1; TCS3
UniProt ID: (Human) Q9NPF4, (Rat) Q9WVS2, (Mouse) Q8BWU5
Entrez Gene ID: (Human) 55644, (Rat) 290028, (Mouse) 66246